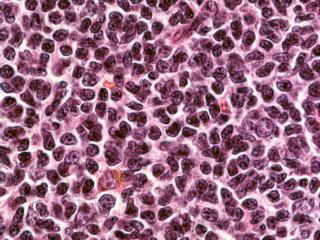

臨床病理診断学講座
講座紹介
昭和医科大学医学部 臨床病理診断学講座はユニークな講座です。まず所属ですが大学院医学研究科としては、病理系臨床病理診断学として基礎医学分野に所属しています。
一方で大学医学部としては、臨床病理診断学講座として臨床講座に所属しています。
医学教育では基礎医学分野としての病理学、病理病態学、病理学実習と担当しています。
一方で臨床医学として病理診断学と臨床検査医学を担当し、卒後教育として臨床研修医の指導も行います。
私たち臨病病理診断学講座は教育・研究を行うだけでなく、病理医、臨床検査医として、昭和医科大学の附属病院の医療を支えています。そのため当講座は、4つの附属病院に4つの診療科を有し、それぞれの診療科で診療科長と診療科長補佐をはじめとする医師が日々診療に従事しています。
講座の構成
大学院医学研究科 病理系臨床病理診断学
医学部 臨床病理診断学 主任教授 矢持淑子
昭和医科大学病院 臨床病理診断科 診療科長 矢持淑子 診療科長補佐 村井 聡
昭和医科大学藤が丘病院 臨床病理診断科 診療科長 診療科長補佐
昭和医科大学横浜市北部病院 臨床病理診断科 診療科長 根本哲生 診療科長補佐 小池千尋
昭和医科大学江東豊洲病院 臨床病理診断科 診療科長 九島巳樹 診療科長補佐 南雲 祐
また、私たちの講座は学内の他の所属の教員にも支えられています。
これらの病理専門医、臨床検査専門医の資格を持つ医師教員は、当講座の教育、研究および診療を支えています。
保健医療学部 福地邦彦 客員教授 (臨床検査医学)
安原 努 准教授(臨床検査医学)
医学部
法医学 松山高明 教授 (病理学)
富士吉田教育部 木村 聡 教授 (臨床検査医学)
歯学部
口腔病理学 美島健二 教授 (口腔病理学)
法人事務局
瀧本雅文 特任教授(病理学)
楯 玄秀 特任教授(病理学)
本田一穂 特任教授(病理学)
令和2年4月、私たちは新たなスタートを切りました。
この大講座には、大きな可能性があります。教育も研究も、診療もこれから発展してまいります。
私たちと一緒に仕事をしませんか。多くの医師の方の参加を心からお待ちしています。
昭和医科大学大学院医学研究科 病理系臨床病理診断学
昭和医科大学医学部 臨床病理診断学
昭和医科大学病院 臨床病理診断科
矢持淑子
昭和医科大学医学部 臨床病理診断学
昭和医科大学病院 臨床病理診断科
矢持淑子
病理医を募集しています
全国で活躍されている病理医の先生方へ
東京、神奈川にある昭和医科大学の附属病院で病理医として活躍しませんか。
多数例の病理組織診断、病理解剖を経験できます。
興味のある方は、矢持淑子 (03-3784-8122, onizuka@med.showa-u.ac.jp)までご相談ください。
・所属は全員が医学部臨床病理診断学講座教員となります。
東京、神奈川にある昭和医科大学の附属病院で病理医として活躍しませんか。
多数例の病理組織診断、病理解剖を経験できます。
興味のある方は、矢持淑子 (03-3784-8122, onizuka@med.showa-u.ac.jp)までご相談ください。
・所属は全員が医学部臨床病理診断学講座教員となります。
・勤務地は人員の適正配置と欠員の有無によって配属が決定されます。いずれも最寄り駅から徒歩圏内で近く、住環境も優れた地域です。
・どこの病院の配属であっても、医学教育は講座として一体になって行います。
・研究は医学部臨床病理診断学講座研究室の施設および学内共同研究施設を利用できます。
① 医学部臨床病理診断学講座・昭和医科大学病院臨床病理診断科(東京都品川区)
② 昭和医科大学藤が丘病院臨床病理診断科(横浜市青葉区)
③昭和医科大学横浜市北部病院臨床病理診断科(横浜市都筑区)
④ 昭和医科大学江東豊洲病院臨床病理診断科(東京都江東区)
・病理専門医取得者と対象としますが、未取得の場合でもご相談ください。
・専門医をお持ちの場合は助教として採用可能です。専門医と学位をお持ちの場合には、欠員状況によって講師としても採用可能です。
研究の紹介
造血器病理
矢持教授、瀧本特任教授、塩沢准教授、本間講師、村井助教が中心になって行っています。非ホジキンリンパ腫の病理形態学的および免疫組織化学的研究、病理検体を用いた分子病理学的手法を用いた研究を行っています。
骨髄病理は急性骨髄性白血病、骨髄異形成症候群、多発性骨髄腫などの研究を行っています。
昭和医科大学内科学血液内科学部門(服部憲路教授)とは継続的な共同研究を行っており、大学院生の研究指導を行っています。また血液内科とは月1回の血液病理カンファレンスを行い、診断困難例や希少症例に関する知見を深めています。
濾胞性リンパ腫 (Pathol Res Pract. 2003 199:293)
急性骨髄性白血病におけるFLT3遺伝子変異の解析 (Leuk Res. 2004 28:997)
循環器病理
昭和医科大学内科学講座 循環器内科学部門(新家俊郎教授)、法医学講座(松山高明教授)と協同し、循環器病理診断および研究活動を行っています。業務内容は心筋生検や弁膜・血管等の循環器検体の診断、および研究として不整脈病理、虚血性心疾患 (特に急性冠症候群) に関する研究を現在積極的に行っています。
不整脈に関しては臨床電気生理学的見地をふまえた刺激伝導系病理学、具体的には不整脈の発生および伝導に関する病理学的な検討およびカテーテルアブレーション治療に関する病理形態学的検討を行っています。
虚血性心疾患に関しては、免疫組織化学を用いてステント等のカテーテル治療後の再狭窄病変の検討や急性冠症候群における血栓成分の検討を行っています。これら研究内容は国内外の学会でおよび学会誌で多く発表しています。

皮膚病理
矢持教授、瀧本特任教授、塩川客員教授が中心となって行っています。皮膚病理診断学を基盤とし、皮膚悪性リンパ腫や皮膚腫瘍の病理学的研究を行っています。
昭和医科大学皮膚科学講座(猪又直子教授)と月1回の皮膚病理カンファレンスを行い、診断困難例や希少症例に関する知見を深めています。
皮膚T細胞性リンパ腫(Pathol Int. 2005 55:32)婦人科病理
2023年4月現在、産婦人科講座と協力しつつ、卵巣癌や不妊(子宮内膜炎や子宮内膜の微細構造について)、子宮頸癌などに関して研究を行っています。漿液性癌の浸潤形態による分類と臨床予後の解析
九島巳樹、南雲佑
本邦における卵巣癌の死亡率は臓器部位別で第10位と決して上位ではありませんが、多くは進行した状態で発見されます。卵巣がんのうち、最も頻度が高い組織型は高異型度漿液性癌で、卵巣悪性上皮性腫瘍の36%を占めます。漿液性癌の化学療法への感受性は高いことが知られていますが、再発などのため、5年生存率は StageⅢ以上の症例では 30-40% 程度となっています。
同じ高異型度漿液性癌においても、化学療法への感受性や再発率、臨床予後には症例ごとに差があることが知られていました。近年、高異型度漿液性癌をその浸潤部の組織形態によってさらに分類する試みがなされ、予後との関係が研究されています。
我々は、同様に当院で摘出された症例についてサブタイピングと臨床予後の解析を行っています。また、浸潤部分における腫瘍間質反応に着目し、とくにがん間質線維芽細胞をターゲットとして、組織形態や免疫組織化学的解析、電子顕微鏡を用いた超微細構造の解析や分子病理学的解析を行い、臨床予後との関連を探っています。
Fig1:High-grade serous carcinoma, mesenchymal transition type (HE, x200)消化器病理
矢持教授、大池客員教授が中心となって行っています。昭和医科大学内科学講座 消化器内科学部門(吉田仁教授)と協同し、鋸歯状腺腫、消化管間葉系腫瘍、MALTリンパ腫、炎症性腸疾患などの臨床病理学的検討を行っています。

乳腺病理
瀧本特任教授が中心になって行っています。昭和医科大学外科学講座 乳腺外科学部門(林 直輝教授、中村清吾特任教授)と協同して乳腺腫瘍の病理診断を行い、乳腺外科と週1回のカンファレンスを通じて、乳腺病理に対する知見を深めています。
分子病理
塩沢准教授、矢持忠徳講師が中心になって行っています。パラフィン包埋組織から抽出した核酸を用いて遺伝子解析を行っています。悪性リンパ腫における免疫グロブリン遺伝子再構成、T細胞受容体遺伝子再構成の検出、病理検体を用いた結核菌遺伝子検査は、病理診断業務における遺伝子診断として分子病理実験室が担当しています。


びまん性大細胞型B細胞リンパ腫におけるp16遺伝子のプロモータ領域CpG islandのDNAメチル化解析 (Leuk Res. 2006 Jul;30(7):859-67.)
沿革
医学部 臨床病理診断学講座は新しい教室ですが、その母体となった講座・部門には長い歴史と実績があります。昭和大学医学部第一病理学教室
昭和医学専門学校時代の早暁期には東大助教授故鈴木遂博士を中心に創設され、東大教授故緒方知三郎博士などが講義を兼任されました。昭和12年 病理学教室専任講師として渡辺五郎氏が着任し、実質的な教室開設となりました。同18年、教授に就任されています。
昭和医科大学時代の昭和21年 渡辺五郎教授、阿部四郎教授の2教室体制で病理学講座を担当、その後阿部教授は退職のため2教室は併設となりました。
昭和28年 一度併設となっていた病理学教室は第一病理学教室(渡辺五郎主任教授)と第二病理学教室(平福一郎主任教授)に分設されました。
昭和医科大学時代になり、昭和50年3月、渡辺五郎教授が定年退職されました。
同年12月に、神田實喜男助教授が第二代主任教授に就任されました。平成7年3月に神田實喜男教授は定年退職されました。
平成7年11月に諸星利男助教授が第三代主任教授に就任されました。
平成24年4月から病理学講座 病理学部門に名称変更されました。
平成25年3月に諸星利男教授は定年退職されました。
昭和大学医学部第二病理学教室
昭和28年に平福一郎先生(当時東京大学病理学助教授)を主任教授に迎えて創設されました。平福教授が昭和29年に日本血液学会総会で、「再生不良性貧血の病理」の演題で宿題報告を行っており、現在でも血液病理学は教室の大きなテーマとして引き継がれています。昭和40年に田代浩二助教授が2代目の教授として昇任されました。昭和46年には現在の総合校舎に移転し、研究設備も当時最新のものが購入され研究活動も盛んとなりました。同時期には厚生省の特定疾患の一つである「再生不良性貧血」調査研究班に加わり、さらに血液病理学の研究が活発になりました。
平成2年に、風間和男員外教授が第2病理学教室の第3代目の主任教授として昇任され、造血臓器の病理のエキスパートとして多くの業績を残されました。
平成6年、太田秀一助教授が第4代目教授に就任され、造血臓器の病理、循環器病理、婦人科病理、消化管病理などを主な研究テーマとし、臨床各科と緊密に連携しながら病理学的研究を展開しました。研究テーマは病理診断に関連したものが多くなり、「病理診断学」を研究テーマとする現在の教室のスタイルが確立されました。太田教授は18年間教室を主宰され、平成24年3月に定年退職されました。
平成24年4月から病理学講座 臨床病理診断学部門に名称変更されました。
昭和大学医学部臨床病理学教室
昭和39年に初代教授として石井暢先生が東京第一病院(現在の国際医療センター)から赴任され、臨床病理学教室がスタートしました。臨床検査を中心とした医学部の講座としては、順天堂大学、日本大学に次いで日本で三番目の開設でした。その後、私立医科大学、国公立大学に相次いで臨床病理学教室、臨床検査医学講座などの名称で臨床検査を研究課題とする講座が開設されたことを考えると、斯界のパイオニアといっても過言ではありません。昭和59年に二代目五味邦英教授が就任され、活発な研究活動、臨床検査業務が行われました。五味教授は昭和医科大学病院院長を務め、大学病院の運営にも尽力され、平成22年に定年退職されました。
平成16年には高木康先生が教授(昭和医科大学医学教育推進室)に就任されました。
平成18年に福地邦彦先生が教授に就任し、昭和医科大学病院の臨床検査部門を管理・指導してきました。
平成24年4月から病理学講座 臨床病理診断学部門に名称変更されました。
昭和大学病院病理診断科
平成9年に昭和医科大学病院に診療科として病院病理科(後に病理診断科に改称)が開設されました。諸星利男教授、太田秀一教授に次いで、九島巳樹准教授が診療科長代理に就任し、第一病理学教室および第二病理学教室とともに昭和医科大学病院、東病院、豊洲病院および烏山病院の病理診断業務を担いました。臨床研修必修化後は、昭和医科大学病院における初期臨床研修医のCPC指導などに中心的な役割を果たしました。昭和医科大学医学部臨床病理診断学講座
平成25年4月に3つの講座(第一病理学、第二病理学、臨床病理学)と6つの診療科(昭和医科大学病院病理診断科、昭和医科大学病院臨床検査科、藤が丘病院病理診断科、藤が丘病院臨床検査科、北部病院病院病理診断科、北部病院臨床検査科)が統合され、1講座3診療科(のちに開院した江東豊洲病院を加えた4診療科)に発展改組されました。初代主任教授には瀧本雅文教授が就任し、昭和医科大学病院臨床病理診断科 診療科長を務めました。藤が丘病院臨床病理診断科 診療科長には大池信之准教授(のちに教授)、北部病院臨床病理診断科 診療科長には国村利明准教授、江東豊洲病院臨床病理診断科 診療科長には九島巳樹教授(のちに特任教授)が就任しました。
平成30年7月に北部病院臨床病理診断科に根本哲生教授(のちに診療科長)が就任されました。
瀧本雅文主任教授は教室の発展に尽力し令和2年3月に定年退職され、特任教授に就任されました。
令和2年4月に北部病院臨床病理診断科に亀山香織教授が就任されました。
令和2年4月、臨床病理診断学講座 第二代主任教授、昭和医科大学病院臨床病理診断科 診療科長として矢持淑子教授が就任しました。
令和7年4月、昭和医科大学医学部 臨床病理診断学講座に名称変更しました。
講座員
教育職員(専任)
| 役職 | 氏名 | name | 業績 (researchmap) |
|---|---|---|---|
| 診療科長・主任教授 (昭和医科大学病院・医学部) | 矢持 淑子 | YAMOCHI Toshiko | https://researchmap.jp/akaringo0523 |
| 准教授 (医学部) | 塩沢 英輔 | SHIOZAWA Eisuke | https://researchmap.jp/Eisuke_SHIOZAWA |
| 准教授・医局長 (昭和医科大学病院) | 本間 まゆみ | HOMMA Mayumi | https://researchmap.jp/mayumi-H |
| 講師 (昭和医科大学病院) | 矢持 忠徳 | YAMOCHI Tadanori | https://researchmap.jp/tyamochi |
| 講師・診療科長補佐
(昭和医科大学病院) | 村井 聡 | MURAI So | https://researchmap.jp/somurai |
| 助教 (医学部) | 佐々木 陽介 | SASAKI Yosuke | https://researchmap.jp/sasakiyosuke |
| 助教 (昭和医科大学病院) | 大平 泰之 | OHIRA Yasuyuki | https://researchmap.jp/y-ohira |
| 助教 (医学部) | 太田 裕崇 | OTA Hirotaka | https://researchmap.jp/patho.html |
| 助教(出張中) (国立がん研究センター東病院) | 小原 淳 | OHARA Jun | https://researchmap.jp/junfrankohara |
| 助教 (昭和医科大学病院) | 解良 仁美
| KERA Hitomi
| https://researchmap.jp/h-kera |
| 助教(医科)
(昭和医科大学病院) | 井上 笙 | INOUE Sho | |
| 助教(医科)
(昭和医科大学病院) | 中山 真悟 | NAKAYAMA Shingo | |
| 助教(医科)
(昭和医科大学病院) | 三由 尚知 | MIYOSHI Naotomo | |
| 助教(医科)
(昭和医科大学病院) | 加藤 倫子 | KATO Michiko | |
| 助教(医科)
(昭和医科大学病院) | 照沼 拓也 | TERUNUMA Takuya | |
| 助教(医科)
(昭和医科大学病院) | 千葉 誠也 | CHIBA Seiya | |
| 助教(医科)
(昭和医科大学病院) | 河森 貴恵 | KAWAMORI Kie | |
| 助教(医科)
(昭和医科大学病院) | 中山 真悟 | NAKAYAMA Shingo | |
| 助教(医科)
(昭和医科大学病院) | 加納 美春 | KANOU Miharu | |
| 助教(医科)
(昭和医科大学病院) | 井関 貞仁 | ISEKI Sadahito | |
| 助教(医科)
(昭和医科大学病院) | 高野 洋次郎 | TAKANO Yojiro | |
| 助教(医科)
(昭和医科大学病院) | 中川 美星子 | NAKAGAWA Mihoko | |
| 助教(医科)
(昭和医科大学病院) | 川又 夏樹 | KAWAMATA Natsuki | |
| 助教(医科)
(昭和医科大学病院) | 酒井 透 | SAKAI Toru | |
| 特任教授
(昭和医科大学病院) | 瀧本 雅文 | TAKIMOTO Masafumi | |
| 特任教授
(昭和医科大学病院) | 本田 一穂 | HONDA Kazuho | https://researchmap.jp/hondakazuho |
| 医局秘書 | 青 暢子 | AO Yoko | |
| 診療科長・特任教授 (江東豊洲病院) | 九島 巳樹 | KUSHIMA Miki | |
| 講師 (江東豊洲病院) | 南雲 佑 | NAGUMO Tasuku | https://researchmap.jp/tnugamo |
| 助教(医科) (江東豊洲病院) | 池田 宏美 | IKEDA Hiromi | |
| 客員教授(歯科医師) (江東豊洲病院) | 河野 葉子 | KOHNO Yohko | |
| 特任教授 (藤が丘病院) | 楯 玄秀 | TATE Genshu | |
| 准教授 (藤が丘病院) | 小川 高史 | OGAWA Takashi | |
| 助教(歯科医師) (藤が丘病院) | 和田あかね | WADA Akane | https://researchmap.jp/Y.Ueda1103 |
| 助教 (藤が丘病院) | 上田 康雄 | UEDA Yasuo | https://researchmap.jp/Y.Ueda1103 |
| 診療科長・教授 (横浜市北部病院) | 根本 哲生 | NEMOTO Tetsuo | https://researchmap.jp/t-nemoto |
| 客員教授 (横浜市北部病院) | 亀山 香織 | KAMEYAMA Kaori | https://researchmap.jp/kaokao |
| 講師 (横浜市北部病院) | 小池 千尋 | KOIKE Chihiro | https://researchmap.jp/zFRV1A2JxCnUfNvb |
| 助教 (横浜市北部病院) | 二本柳 康博 | NIHONYANAGI Yasuhiro | https://researchmap.jp/nihonyanagi_1967 |
| 名誉教授 | 諸星 利男 | MOROHOSHI Toshio | |
| 名誉教授 | 太田 秀一 | OTA Hidekazu | |
| 名誉教授 | 光谷 俊幸 | MITSUYA Toshiyuki | |
| 客員教授 | 塩川 章 | SHIOKAWA Akira | |
| 客員教授 | 国村 利明 | KUNIMURA Toshiaki | |
| 客員教授 (聖マリアンナ医科大学) | 大池 信之 | OHIKE Nobuyuki | |
| 客員教授 | 相田 順子 | AIDA Junko | |
| 客員教授 (帝京大学医学部) | 笹島 ゆう子 | SASAJIMA Yuko | |
| 客員教授 (東海大学医学部) | 田尻 琢磨 | TAJIRI Takuma | |
| 客員教授 | 長田 道夫 | NAGATA Michio | |
| 客員教授 | 秋山 太 | AKIYAMA Futoshi | |
| 客員教授 (東京都立豊島病院) | 鄭 子文 | TEI Shikofumi | |
| 客員教授 | 三富 弘之 | MITOMI Hiroyuki | |
| 兼任講師 | 高桑 恵美 | TAKAKUWA Emi | |
| 兼任講師 (東京都立豊島病院) | 秋田 英貴 | AKITA Hidetaka | |
| 兼任講師 (東海大学医学部) | 杉山 朋子 | SUGIYAMA Tomoko | |
| 兼任講師 (聖マリアンナ医科大学) | 野呂瀬 朋子 | NOROSE Tomoko | |
| 兼任講師 (NTT東日本関東病院) | 三浦 咲子 | MIURA Sakiko | |
| 兼任講師
(伊藤病院) | 川井田 みほ | KAWAIDA Miho | |
| 兼任講師 | 岸本 浩司 | KISHIMOTO Koji | |
| 兼任講師
(東京大学医科学研究所付属病院) | 前島 亜希子 | MAESHIMA Akiko |
研究生
大学院生: 31名入局案内
臨床病理診断学講座 入局者募集
臨床病理診断学講座では広く医局員を募集しています。当教室に入局するには目的に応じていくつかの方法があります。入局を希望される方は医局長ないし教授にご相談ください。大学院生としての入局を希望される場合には定員がありますので、早めに相談してください。病理医・専攻医募集しています。
臨床研修を修了した医師、現在臨床科の医師で病理への転科を希望する医師を募集しています。
病理専門医、細胞診専門医取得の指導をいたします。学位取得も可能です。
臨床病理診断科医局 担当 矢持淑子または本間まゆみ 03-3784-8122 まで御連絡ください。
よくある質問
入局に関するよくある質問と答えすべて開く +
大学院・研究生について
Q.誰でも大学院に入学できますか?
A.当教室は診断病理学を研究・診療活動の主体としていますので、基本的に医師免許取得者を対象としています。医師免許を持ち、臨床研修を修了していないと病理診断業務に参加できず、研究活動に制約が生じる可能性があります。Non-MDの方は研究生として標本作成技術、免疫組織化学技術、分子病理診断技術などの研究に従事する方法もありますのでご相談ください。
Q.大学院への入学は試験のみですか?
A.大学院の入学試験は書類審査、筆記試験(英語)、面接で行います。特に面接を重視し、志願者の将来に対するビジョンと当教室の方針・研究内容が一致することが重要です。病理学に関する専門知識は必要ありません。いきなり大学当局に出願手続きをするのではなく、出願前に必ず、医局長もしくは教授にご相談ください。
Q.社会人大学院枠で入学したいのですが、臨床研修医との両立は可能でしょうか。
A.可能です。臨床研修医の2年間は夜間や土曜日に大学院医学研究科が認定するセミナーやレクチャーに参加して所定の単位を取得します。研究は主に3-4年目から開始しますので、臨床研修期間中は臨床医学の習得に専念できます。学位は最短で卒後4年間で取得可能です。
Q.学位研究のための研究のみを行いたいのですが。
A.当教室では将来に病理専門医を目指す場合はもちろんのこと、学位取得後に臨床医学に戻る予定である場合でも、大学院生・研究生は学位研究のみならず、昭和医科大学病院病理診断科医員としての業務があります。これらの業務は病理形態学的研究と密接に関わっていますので、研究のための基礎的技術として習得が欠かせないものです。研究以外の業務には以下のものがあります。
学位研究以外はやりたくない方、純粋な基礎研究(分子生物学、実験病理学など)のみを希望される方は他の研究室も検討されることをお勧めします。
A.当教室は診断病理学を研究・診療活動の主体としていますので、基本的に医師免許取得者を対象としています。医師免許を持ち、臨床研修を修了していないと病理診断業務に参加できず、研究活動に制約が生じる可能性があります。Non-MDの方は研究生として標本作成技術、免疫組織化学技術、分子病理診断技術などの研究に従事する方法もありますのでご相談ください。
Q.大学院への入学は試験のみですか?
A.大学院の入学試験は書類審査、筆記試験(英語)、面接で行います。特に面接を重視し、志願者の将来に対するビジョンと当教室の方針・研究内容が一致することが重要です。病理学に関する専門知識は必要ありません。いきなり大学当局に出願手続きをするのではなく、出願前に必ず、医局長もしくは教授にご相談ください。
Q.社会人大学院枠で入学したいのですが、臨床研修医との両立は可能でしょうか。
A.可能です。臨床研修医の2年間は夜間や土曜日に大学院医学研究科が認定するセミナーやレクチャーに参加して所定の単位を取得します。研究は主に3-4年目から開始しますので、臨床研修期間中は臨床医学の習得に専念できます。学位は最短で卒後4年間で取得可能です。
Q.学位研究のための研究のみを行いたいのですが。
A.当教室では将来に病理専門医を目指す場合はもちろんのこと、学位取得後に臨床医学に戻る予定である場合でも、大学院生・研究生は学位研究のみならず、昭和医科大学病院病理診断科医員としての業務があります。これらの業務は病理形態学的研究と密接に関わっていますので、研究のための基礎的技術として習得が欠かせないものです。研究以外の業務には以下のものがあります。
- 病理組織診断業務(細胞診を含む)
- 病理解剖業務(病院におけるCPCを含む)
- 医学部生教育(病理学実習、BSL)
- 臨床研修医の教育(CPCレポート指導)
- 看護教育(看護学校における講義)
- その他、医局員としての業務
学位研究以外はやりたくない方、純粋な基礎研究(分子生物学、実験病理学など)のみを希望される方は他の研究室も検討されることをお勧めします。
病理医について
Q.病理医の業務について教えてください。
A.臨床医学には大きく分けて診断学と治療学があります。診断学に属する病理組織診断は医師のみが行える医行為であり、臨床医学における確定診断(最終診断)となる重要なものです。決して基礎医学者ではありません。放射線科医が行う画像診断が診療行為であるのと同様に、病理医の病理組織診断は診療行為です。内科や外科などの一般の臨床医と比較して異なる点は
などが挙げられます。
Q.女性医師ですが、将来仕事と家庭の両立は可能でしょうか。
A.病理医は女性医師の活躍が進んでいる分野で、多くの指導的立場の女性医師が全国で活躍しています。当教室でも女性医師は中心的な役割を果たしています。病理医としての業務に性別は関係ありません。病理医の業務は勤務時間よりも仕事量に依存していますので、時間を上手くやりくりして家庭生活・育児との両立も十分に可能です。もちろんだからといって決して「楽な仕事」ではなく、他の臨床医と同様に十分な研修期間と高い見識が要求されるのは当然です。
Q.現在、臨床医をしている10年目の医師ですが、いまから病理医になれますか。
A.なれます。臨床医経験者は大歓迎です。病理医として独立するためには病理専門医の資格取得は必須で、5~7年程度の病理研修期間が必要です。しかし病理医は第一線で活躍できる期間が長く、高齢の医師でも研鑽を怠らなければ高いレベルの医療活動が可能です。
Q.自分は臨床に向かないと思うので病理などを希望しているのですが。
A.独断ではありますが、一般に「臨床に向かない」と思われる方は病理医にも向かないと思います。病理医は病理診断を行う臨床医です。精神科を除く全科にわたる広い医学知識に基づいた疾患の理解がないと臨床医から信頼される病理診断はできません。また病理専門医試験の受験資格に厚生労働省の臨床研修修了は必須条件となっています。
Q.基礎医学に進むと生活ができないと聞いているので心配です。
A.心配ありません。繰り返しになりますが病理医は病理組織診断を行う臨床医であり、病理診断は医師しかできない医行為です。病理専門医の収入はほかの臨床勤務医と比較しても遜色ないものです。他の基礎医学者と異なり、大学・研究機関以外に市中病院に勤務することが可能です。病理専門医はその高い専門性と希少性から臨床の現場からも高く評価されています。病理医は絶対的な不足が続いていますので実力さえあれば大病院の検査部長や外注検査会社専属の病理診断医として活躍でき、それに見合う十分な対価が得られます。病理専門医を取得するまでの研修期間は臨床の非常勤バイト、医局関連病院での病理診断や病理解剖の補助で手当てが支給されます。詳しくは医局長に相談してください。
Q.わたしは医学生(研修医)ですが、病理医の仕事のイメージが掴めず、進路選択としては不安です。
A.なにはともあれ、病理医に興味があるならぜひ当教室で実際に活動している病理医に会いにきてください。もしあなたが、研修医なら研修病院の病理医にぜひ会ってみてください。きっと臨床の現場で活躍する病理医の姿が理解できます。
A.臨床医学には大きく分けて診断学と治療学があります。診断学に属する病理組織診断は医師のみが行える医行為であり、臨床医学における確定診断(最終診断)となる重要なものです。決して基礎医学者ではありません。放射線科医が行う画像診断が診療行為であるのと同様に、病理医の病理組織診断は診療行為です。内科や外科などの一般の臨床医と比較して異なる点は
- 直接患者さんに接する機会が少ない
- 他科の臨床医からのコンサルトを受けることが多い(Doctor's doctor)
- 医学教育(医学部生、研修医)の比重が高い
などが挙げられます。
Q.女性医師ですが、将来仕事と家庭の両立は可能でしょうか。
A.病理医は女性医師の活躍が進んでいる分野で、多くの指導的立場の女性医師が全国で活躍しています。当教室でも女性医師は中心的な役割を果たしています。病理医としての業務に性別は関係ありません。病理医の業務は勤務時間よりも仕事量に依存していますので、時間を上手くやりくりして家庭生活・育児との両立も十分に可能です。もちろんだからといって決して「楽な仕事」ではなく、他の臨床医と同様に十分な研修期間と高い見識が要求されるのは当然です。
Q.現在、臨床医をしている10年目の医師ですが、いまから病理医になれますか。
A.なれます。臨床医経験者は大歓迎です。病理医として独立するためには病理専門医の資格取得は必須で、5~7年程度の病理研修期間が必要です。しかし病理医は第一線で活躍できる期間が長く、高齢の医師でも研鑽を怠らなければ高いレベルの医療活動が可能です。
Q.自分は臨床に向かないと思うので病理などを希望しているのですが。
A.独断ではありますが、一般に「臨床に向かない」と思われる方は病理医にも向かないと思います。病理医は病理診断を行う臨床医です。精神科を除く全科にわたる広い医学知識に基づいた疾患の理解がないと臨床医から信頼される病理診断はできません。また病理専門医試験の受験資格に厚生労働省の臨床研修修了は必須条件となっています。
Q.基礎医学に進むと生活ができないと聞いているので心配です。
A.心配ありません。繰り返しになりますが病理医は病理組織診断を行う臨床医であり、病理診断は医師しかできない医行為です。病理専門医の収入はほかの臨床勤務医と比較しても遜色ないものです。他の基礎医学者と異なり、大学・研究機関以外に市中病院に勤務することが可能です。病理専門医はその高い専門性と希少性から臨床の現場からも高く評価されています。病理医は絶対的な不足が続いていますので実力さえあれば大病院の検査部長や外注検査会社専属の病理診断医として活躍でき、それに見合う十分な対価が得られます。病理専門医を取得するまでの研修期間は臨床の非常勤バイト、医局関連病院での病理診断や病理解剖の補助で手当てが支給されます。詳しくは医局長に相談してください。
Q.わたしは医学生(研修医)ですが、病理医の仕事のイメージが掴めず、進路選択としては不安です。
A.なにはともあれ、病理医に興味があるならぜひ当教室で実際に活動している病理医に会いにきてください。もしあなたが、研修医なら研修病院の病理医にぜひ会ってみてください。きっと臨床の現場で活躍する病理医の姿が理解できます。
研究業績
すべて開く +
2024年業績
論文
【食道癌2024-基礎・臨床の最新動向-】食道腫瘍の病理 SSBE-腺癌Author:小原 淳(昭和大学 臨床病理診断学講座), 根本 哲生
Source:日本臨床(0047-1852)82巻増刊3 食道癌2024 Page108-114(2024.05)
A case report of recurrent thymoma with peritoneal dissemination despite undergoing multimodality therapy
Akihiro Nakamura, Akane Wada, Yasuo Ueda, and Takafumi Ogawa
2024年 Showa University Journal Medical Science
A rare case of signet ring cell carcinoma of the transverse colon with concentric intramural metastases
Sadahito Iseki, Takeshi Aoki, Makoto Watanabe, Kohei Ono, Hideki Shibata, Takahito Hirai, Yoshiaki Ozawa, Tetsuya Kitajima, Suguru Sasamoto, Yuta Enami
Showa Medical University Journal 37(1): 33-37, March 2025
Ohara J, Maeda Y, Ogata N, Kuroki T, Misawa M, Kudo SE, Nemoto T, Yamochi T, Iacucci M. Automated Neutrophil Quantification and Histological Score Estimation in Ulcerative Colitis. Clin Gastroenterol Hepatol. 2025 Apr;23(5):846-854.e7.doi: 10.1016/j.cgh.2024.06.040. Epub 2024 Jul 25. PMID: 39059545.
Sasaki Y, Murai S, Hayashi H, Kawamata N, Nagao K, Kuroiwa K, Narita H, Okamura R, Shimada S, Watanuki M, Arai N, Kawaguchi Y, Yanagisawa K, Shiozawa E, Yamochi T, Hattori N. Clinicopathological differences in MYC and BCL2 protein expression between primary extranodal and nodal diffuse large B-cell lymphoma.
Pathol Res Pract. 2024 Aug;260:155425. doi: 10.1016/j.prp.2024.155425. Epub 2024
Jun 25. PMID: 38964118.
Narita H, Kuroiwa K, Kawaguchi Y, Murai S, Sasaki Y, Homma M, Kawamata N, Hayashi H, Nagao K, Okamura R, Uesugi Y, Sasaki Y, Shimada S, Watanuki M, Arai N, Yanagisawa K, Shiozawa E, Yamochi T, Hattori N. High Ki-67 Expression Predicting a Risk Factor for the Progression of Disease within 24 Months and Microenvironment in Follicular Lymphoma. Int J Mol Sci. 2024 Oct 15;25(20):11057. doi: 10.3390/ijms252011057. PMID: 39456838; PMCID: PMC11507466.
Natori I, Tanioka D, Kobayashi Y, Shimizu K, Mizutani T, Omatsu M, Nemoto T. Histiocytic sarcoma of the suprasellar region: illustrative case. J Neurosurg Case Lessons. 2025 Mar 24;9(12):CASE24297. doi: 10.3171/CASE24297. PMID: 40127477; PMCID: PMC11933653.
Yamochi T, Ugajin K, On R, Inoue S, Ikeda H, Yamochi T, Takimoto M, Tokimatsu I. Impact of meropenem exposure on fluoroquinolone and carbapenem resistance in Pseudomonas aeruginosa infection in inpatients in a Japanese university hospital: Insights into oprD mutations and efflux pump overexpression. J Glob Antimicrob Resist. 2025 Mar;41:163-168. doi: 10.1016/j.jgar.2024.12.029. Epub 2025 Jan 14. PMID: 39818330.
Azami T, Takano Y, Tamai N, Noda J, Yamawaki M, Niiya F, Nishimoto F, Maruoka N, Ogawa T, Nagahama M. Intracholecystic papillary neoplasm associated with an invasive carcinoma with cholecystocolonic fistula: a case report. Clin J Gastroenterol. 2025 Feb;18(1):188-194. doi: 10.1007/s12328-024-02079-7. Epub 2024 Dec 12. PMID: 39668313.
Tanaka K, Takahashi Y, Nakamura A, Minegishi Y. Liver anatomy for totally laparoscopic segment 7 resection from a caudal magnified view-a 3-dimensional computed tomographic analysis. Surg Endosc. 2024 Dec;38(12):7366-7374. doi: 10.1007/s00464-024-11333-5. Epub 2024 Oct 21. PMID: 39433586.
Ueda Y, Shimoyama H, Takeyama N, Ogawa T. Primary classical seminoma of the testis with rhabdoid differentiation. BMJ Case Rep. 2024 Dec 24;17(12):e260440. doi: 10.1136/bcr-2024-260440. PMID: 39719389.
Prolonged Survival in Postoperative Recurrent EGFR-L858R NSCLC: A 24-Year Case Report
Yoshihiro Go, Chinatsu Yoshizaki, Yuki Yoshida, Shiho Nohmi, Rui Kusakado, Yuichiro Saito, Kensuke Izumizaki, Takafumi Ogawa, Takashi Suzuki, Fumihiro Yamaguchi
2024 Current Problems in Cancer: Case Reports
Recurrent thymoma with peritoneal dissemination despite undergoing multimodal therapy: A case report
NAKAMURA Akihiro, WADA Akane, UEDA Yasuo, OGAWA Takafumi
Showa Med Univ J 37(1)p38-43
Retrospective study on the background pancreas on endoscopic ultrasonography in pancreatic tumors
NAKAYAMA Akihiro, MITSUI Yuta, IIDAKA Masanori, NOGUCHI Toshihiro, NAKATANI Kei, NISHIHARA Shigetoshi, OIKAWA Shu, USAMI Tomono, ISHII Yu, OHIRA Yasuyuki, YAMOCHI Toshiko, YOSHIDA Hitoshi
Showa Univ J Med Sci 36(3)p110-116
Misawa A, Shingo M, Miyamura T, Ogawa T, Morioka M. Small Cell Carcinoma of the Ovary, Pulmonary Type, With a Germline BRCA2 Mutation: A Report of a Rare Case. Cureus. 2025 Feb 12;17(2):e78894. doi: 10.7759/cureus.78894. PMID: 40091949; PMCID: PMC11908406.
ハイパースペクトルイメージを使用した前立腺の腺癌と神経内分泌腫瘍の新たな識別方法の検討
Author:谷藤 暁(昭和大学 大学院医学研究科医学専攻(臨床病理診断学分野)), 小川 高史, 野呂瀬 朋子, 和田 あかね, 下山 英明, 上田 康雄, 楯 玄秀, 佐々木 春明, 矢持 淑子
Source:昭和学士会雑誌(2187-719X)84巻4号 Page296-304(2024.)
リンパ腫骨髄浸潤評価における骨髄検査およびPositron-emission tomography/Computed tomography検査の後方視的解析
Author:上杉 由香(昭和大学 医学部生理学講座生体調節機能学部門), 村井 聡, 成田 雛子, 黒岩 魁, 岡村 玲子, 佐々木 陽平, 島田 翔太郎, 綿貫 めぐみ, 川口 有紀子, 荒井 奈々, 藤原 峻, 柳沢 孝次, 塩沢 英輔, 矢持 淑子, 泉崎 雅彦, 服部 憲路
Source:昭和学士会雑誌(2187-719X)84巻4号 Page337-347(2024.)
鑑別困難であった思春期乳房の結節性筋膜炎の1例
Author:島田 雅之(昭和大学 医学部外科学講座乳腺外科部門), 永田 彩, 成井 理加, 小川 高史, 白 英, 榎戸 克年
Source:日本臨床外科学会雑誌(1345-2843)86巻4号 Page482-488(2025.04)
上唇に発生した多形腺腫の1例
Author:根本 結基(昭和大学 歯学部口腔外科学講座顎顔面口腔外科部門), 堅田 凌悟, 小島 啓二朗, 伊藤 美莉, 佐藤 仁, 相田 順子, 根本 哲生, 代田 達夫
Source:昭和医科大学雑誌(2759-8144)85巻1号 Page59-65(2025.)
大腸管状腺癌および管状腺腫におけるCD71/transferrin receptor 1発現と病理組織診断への応用に関する臨床病理学的検討 ―腺腫内癌におけるCD71発現の比較検討を用いて―
望月 裕一朗, 塩沢 英輔, 北條 真鈴, 佐々木 陽介, 片桐 敦, 吉田 仁, 浦上 尚之, 横山 登, 井上 晴洋, 矢持 淑子
2024年7月 昭和学士会雑誌 84(3)p242-252